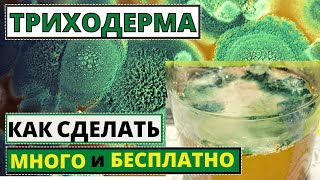

КАК САЖАТЬ РОДИОЛУ РОЗОВУЮ ПРАВИЛЬНО
Родиола розовая, или золотой корень, является популярным лекарственным растением садоводов и огородников. Ее сажают для получения полезных корней, которые широко применяются в традиционной медицине. Вот несколько шагов, которые помогут вам правильно посадить родиолу розовую.
1. Выберите подходящее место: родиола розовая предпочитает солнечные или полутенистые места с плодородной почвой и хорошим дренажем.
2. Подготовьте почву: перекопайте и улучшите почву органическими удобрениями, чтобы создать оптимальные условия для роста растения.
3. Время посадки: родиолу розовую можно сажать весной или осенью, когда почва достаточно прогрелась и остыла.
4. Размещение растений: оставьте достаточное расстояние между растениями, примерно 30-40 см, чтобы обеспечить хорошую вентиляцию и рост растений.
5. Способ посадки: сделайте небольшую ямку и аккуратно поместите корень растения в ямку так, чтобы корневая шейка оказалась на уровне почвы. Затем накройте корни почвой и утрамбуйте ее.
6. Полив: обеспечьте достаточный полив после посадки и в период сухости. Но избегайте залегания воды, чтобы не вызвать гниение корней.
7. Уход за растением: регулярно пропалывайте сорняки, рыхлите почву и удобряйте родиолу розовую органическими или минеральными удобрениями.
Следуя этим простым рекомендациям, вы сможете успешно посадить родиолу розовую и наслаждаться ее красивыми и полезными корнями.
Этот цветок выращивать ВЫГОДНЕЕ ВСЕГО!
Как посадить родиолу розовую, золотой корень
Родиола розовая- от утомления, тревоги и депрессии.
Золотой Корень Деление и Пересадка
Имбирь вместо Виагры. Супер свойства имбиря для железного стояка.
Золотой корень. Родиола розовая
Родиола розовая, Золотой корень - лечебные свойства, применение, противопоказания - советы врача.